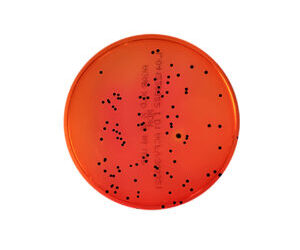
Casos de Salmonella y Shigella: recomendaciones para evitar su propagación

Esto es lo que diferencia la miel natural de la artificial
Descubre si la miel que tienes en casa es pura o ha sido adulterada con azúcar y siropes de dudosa calidad. En las redes hay varios vídeos que te ayudan a identificar la miel de verdad.
Luis Camera sobre la nueva vacuna contra el dengue: «Es para los cuatro serotipos que circulan en el país»
El miércoles la ANMAT autorizó el uso de la vacuna japonesa para todas las personas mayores de 4 años.
Para combatir el dengue, Brasil liberará a cinco mil millones de mosquitos modificados en los próximos 10 años
Una revista internacional publicó un estudio en el que informa que la bacteria Wolbachia impide que el mosquito transmita el virus.
Alerta dengue: ya son 39 los muertos en el país y los especialistas advierten sobre la presencia de un nuevo genotipo del virus
El Ministerio de Salud indicó que se trata de la cepa DENV-2 que provoca la mayor cantidad de casos. Salta y Tucumán registran el número más alto de fallecidos.
Insectos: por qué se estudian como alimento alternativo a la carne
La FAO promueve la producción para el consumo de seres humanos por ser nutritivos y sustentables. En muchos países forman parte de sus dietas ancestrales. En otros existen barreras culturales que bloquean su introducción, aunque tienden a romperse
El Gobierno considera que el brote de dengue «no está controlado»
Así lo precisó la ministra de Salud, Carla Vizzotti, en la previa a un nuevo encuentro del Cofesa en Casa Rosada, y aclaró trabaja para minimizar el impacto.
Siete hierbas y especias que tienen más calcio que un vaso de leche
El calcio es un mineral de gran importancia para nuestro cuerpo que podemos incorporar no sólo con los lácteos. Por eso, te mostramos cuáles son las hierbas y especias con más calcio que un vaso de leche.
Pautas para la prevención del síndrome urémico hemolítico y cuidar la salud de las personas
El Senasa recuerda que es clave un consumo seguro y responsable de alimentos para no contraer esta enfermedad.
Dengue y chikungunya: la tarea del Instituto Maiztegui en el diagnóstico
El Inevh coordina la red nacional de laboratorios para el estudio de arbovirus y por sus capacidades no solo procesa muestras para confirmar casos, sino que puede realizar el aislamiento de la cepa viral y caracterizarla genéticamente. Profesionales de esta institución describieron este rol y abundaron sobre la situación epidemiológica regional que motivó una alerta del Ministerio de Salud.
Casos de Salmonella y Shigella: recomendaciones para evitar su propagación
En los últimos días del mes de enero se registraron en la provincia de Buenos Aires cuatro casos de estas enfermedades en personas adultas, a causa del consumo de achuras contaminadas con las bacterias del género Salmonella y Shigella, siendo dos de ellos mortales.
Pautas para la prevención de la brucelosis caprina y el cuidado de la salud de las personas
Recomendaciones brindadas por el Senasa para conocer más detalles sobre la enfermedad transmitida por alimentos y evitar contagiarse.
Oro, incienso y mirra: usos medicinales
Cuenta la historia, que los Reyes Magos trajeron oro, incienso y mirra como ofrendas para agasajar al recién nacido niño Jesús. Hoy en día, los científicos consideran muy valiosas a estas sustancias por sus propiedades para tener una vida saludable
Día Mundial del Veganismo, una tendencia que crece
Entonces, si la alimentación vegana se encuentra bien planificada y supervisada por un profesional de la salud, los nutrientes que se consideran más críticos como Calcio, Hierro, Omega 3 y Vitamina B 12, pueden cubrirse sin ningún inconveniente.
Llega el verano y con él, las dietas locas. ¿Por qué hacer dieta no es una opción?
Por la Dra. Busnelli